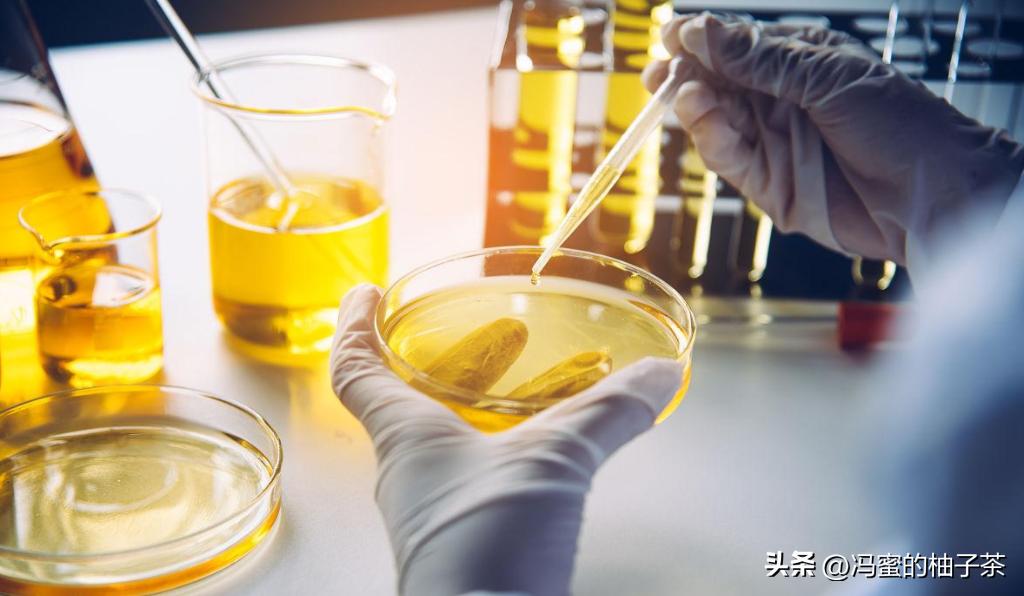
食用油中的含钾高吗,一般植物油中含磷钾的量是多少

钾、钠是维持人体体液平衡并参与神经信息传递的必需微量电解质元素,是通过食物摄取而引入人体的,在许多预包装食物袋标示的营养成分表中为常见的2种金属元素成分。
然而,在常见食用植物油的营养成分表中钾、钠元素标示量及营养素参考值常标示为0,这与现行食用植物油的金属元素国家标准检测方法和食用植物油中金属元素实际含量均有一定影响。

在食用植物油中微量金属元素分析方法中样品前处理技术尤为重要,当前多为酸化消解法、干法灰化法、浊点微萃取法等,上述一些方法中可能会使用大量的酸消解处理,加之待分析无机元素成分含量相对较低,易导致待测液背景值偏高,样品前处理周期较长(5h以上,甚至放置过夜),样品前处理时取样量又较少(约1g),以至于分离出的待测液中金属离子浓度可能低于分析方法检出限,给钾、钠等无机金属元素的分析工作带来诸多不便。
试验根据从非极性物质为主体的介质中分离微量极性组分,结合传统液液萃取及反胶束萃取技术的优点,提出利用反胶束萃取体系提取分离富集食用植物油中的钾、钠元素,建立一种食用植物油中无机金属元素的快速分离及分析检测方法,为食用植物油中金属元素分析及其营养成分评价提供一定技术支撑。
主要试剂与仪器:超声波提取仪;原子吸收分光光度计;2-噻吩甲酰三氟*酮丙**;18-冠醚-6;15-冠醚-5;硝基苯(分析纯)、*水氨**(分析纯)、氯化铵(分析纯)、正辛醇(分析纯)、钾(钠)离子标准溶液。
称取一定量的螯合剂18-冠醚-6(浓度为7mmol/L)和20mL分散剂正辛醇溶于100mL容量瓶中,并用硝基苯溶剂定容。即配制完成用于萃取钾、钠元素的反胶束萃取液。

准确移取15mL的食用植物油于125mL分液漏斗中,加入6.0mL反胶束萃取液,加入氨-氯化氨缓冲溶液调节提取液pH为9.0,置于超声波提取仪并设置超声波频率40kHz,在室温条件下超声提取10min,静置,待分层后,取出反胶束层。
然后加入20mL的去离子水,在转速200r/min的恒温摇床中振荡25min后,置于分液漏斗中静置,待分层后再定量反萃取2次,合并水相层,并用滤头将水相进行过滤备用,取滤液测定金属钾、钠元素含量。
用火焰原子吸收分光光度计测定反胶束萃取液中金属元素,取平行测定3次的平均值计算钾、钠元素浓度,计算公式如式(1)所示;以国家标准方法测定植物油中钾、钠元素含量为参考标准值,建立的反胶束萃取法测定的钾、钠元素含量为测量值,计算反胶束萃取法萃取钾、钠元素的萃取率,计算公式如式(2)所示。

选择性萃取分离非极性基体油脂中的有机金属化合物,需选择能与钾、钠元素有较强的配位作用螯合剂,且该螯合剂同时具备既能在非极性疏水介质中有一定溶解度,又能溶解在极性亲水性介质,所以试验选取了具有双亲性特性的冠醚类螯合剂。
试验考察了噻吩甲酰三氟*酮丙**、18-冠醚-6、15-冠醚-5等3种螯合剂,按照反胶束萃取液配制方法配制螯合剂浓度为5mmol/L的反胶束萃取液,按照萃取分离植物油中钾、钠的分离分析方法进行试验。

可以看出,对钠离子萃取效果,18-冠醚-6与15-冠醚-5萃取效果相当,且萃取效果均优于TTA;对于钾离子的萃取,18-冠醚-6的萃取效果明显优于15-冠醚-5和TTA。
由于不同冠醚的空穴直径大小有一定差异性,18-冠醚-6空穴直径稍大于15-冠醚-5,以及钠、钾离子的直径与18-冠醚-6的空穴直径相当且能发生较强的螯合作用。综合比较,选取18-冠醚-6作为试验萃取植物油中钾、钠离子的螯合剂。

在反胶束萃取过程中反胶束数量多少与螯合剂浓度大小有一定相关性,试验分别配制浓度为2,5,7和9mmol/L的18-冠醚-6/硝基苯/正辛醇的反胶束溶液,考察它们对反胶束萃取的影响,并按照萃取分离植物油中钾、钠离子分离分析方法进行试验。
通过试验发现:随着18-冠醚-6浓度的增加,萃取率呈逐渐增大趋势,且所萃取出的钠离子的含量比钾离子高;当18-冠醚-6的浓度增大至7mmol/L时植物油中的钾、钠离子萃取率达到最大。

18-冠醚-6的浓度较低时,溶液中的反胶束形成数目随着18-冠醚-6浓度的增大而增多,增溶螯合钾、钠离子的能力随之增强;而当18-冠醚-6的浓度达到一定(7mmol/L)后,在体系水分浓度基本不变的条件下,随着18-冠醚-6浓度的增大,水的含量变小,萃取率增大不明显甚至减少,可能由于溶液中反胶束内核尺寸变小,萃取率下降以至达到平衡。
综合比较,选取18-冠醚-6反胶束溶液浓度7mmol/L作为试验萃取植物油中钾、钠离子的最佳反胶束溶液浓度。

为保证植物油中钾、钠金属离子全部转移到反胶束溶液中,反胶束溶液用量要合适且不可过多。试验分别考察了3,4,5和6mL反胶束溶液对萃取钾、钠离子影响,并按照萃取分离植物油中钾、钠离子分离方法进行试验。
可以看出,随着反胶束溶液用量的增大,萃取出的植物油中钾、钠离子的含量呈上升趋势,且所萃取出的钠离子的含量较钾离子高。反胶束用量过少,所形成的反胶束数目也少,钾、钠离子可能并未完全增溶进入,不能最大量被萃取出来;反胶束用量过多,则会导致反胶束数量增多,造成钾、钠离子增溶困难,且对试剂也是一种浪费。
综合比较,选取6.00mL反胶束溶液作为试验萃取植物油中钾、钠离子的最佳反胶束溶液用量。

在以非极性基体物质萃取极性金属元素时,萃取液的pH对金属元素的相转移、在两相中溶解度及分离效果有较大影响。
试验考察了pH为8.0,9.0,10.0和11.0的反胶束萃取溶液体系,并按照萃取分离植物油中钾、钠离子分离分析方法进行试验。
通过萃取和反萃取的试验现象发现:pH8时萃取和反萃取分层速度较快,随着pH的增加,分层速度逐渐变慢;当pH11时,基本上未分层且水相浑浊;当pH9时,该试验条件下的钾、钠离子萃取率均达到最大值,且萃取出的钠离子的含量比钾离子高。

说明在pH较小时,钾、钠离子与18-冠醚-6的配位作用力弱,萃取率偏小;且pH过大时体系容易产生乳化,有机相与水相不易分开,无法实现萃取分离效果。
在pH9条件下钾、钠离子在反胶束中的浓度大于在植物油和水相中的浓度,反萃取时钾、钠离子不断从反胶束中迁移进入水相,使得钾、钠离子最大量地被萃取到水相中。
故选取pH9作为试验反胶束溶液的最佳pH。

在反胶束萃取过程中,缓冲溶液用量影响反胶束溶液的离子强度,进而也影响金属离子在不同相态的萃取分离速度。
在萃取时分别考察了1~6mL(间隔体积为1mL)不同用量的缓存溶液对反胶束萃取的影响,并按照萃取分离植物油中钾、钠离子分离分析方法进行试验。
可以看出,随着缓冲溶液用量的增加,钾、钠离子的萃取率也增大,且所萃取出的钠离子的含量比钾离子高。

可能因为加大缓冲溶液用量一方面促使体系中离子强度增加,形成的反胶束体积增大,数量减少;且反胶束集团内外离子浓度相差大,形成了传质推动力,使钾、钠离子更高效地进入反胶束中;另一方面体系中水的含量也增大,所形成的反胶束内核尺寸变大,能有更大的空间与离子相结合,提高对钾、钠离子的萃取率;达到5~6mL范围时钾、钠离子萃取效率趋于稳定。
综合比较,选取缓冲溶液5mL作为试验萃取植物油中钾、钠离子的最佳缓冲溶液用量。

为加快反胶束萃取速度,可利用超声波的定向传播及超强的穿透能力,加速反胶束与目标离子的作用。试验分别考察了5,10,20和30min不同超声辅助萃取时间对萃取分离钾、钠离子的影响。
通过试验发现:随着超声时间的增加,钾、钠离子的含量变化趋势基本一致,均在10min时所萃取出的含量最大,且钠离子的含量比钾离子高。在超声10min之后的钾、钠离子的溶解基本达到饱和,且随着超声时间的延长,体系中会出现一定程度的乳化现象,导致分层不明显,无法完全萃取分离。
故选取超声辅助萃取10min作为试验萃取植物油中钾、钠离子的最佳超声辅助萃取时间。

超声波频率是影响待分离成分萃取效率的主要因素,按照萃取试验方法分别考察了30,40,50和60kHz等不同频率对钾、钠离子萃取分离的效果。
可以看出,随着超声频率的增加,钾、钠离子的萃取率变化趋势基本相同,且在40kHz时萃取率最大,而后减小至基本趋于平缓,且所萃取出的钠离子的含量较钾离子高。
由于超声的空化效应和机械效应会增大水油两相界面间的湍动,同时空化产生的微射流加速油脂的运动,其中金属离子也随之加速扩散,更好地增溶进入水相,提高萃取率。但当反胶束与溶解的钾、钠离子达到饱和后,振动频率的增加会使体系产生乳化。故选取40kHz作为试验萃取植物油中钾、钠离子的最佳超声振动频率。

按照国家标准方法及所建立的反胶束萃取分析方法,分别对市售常见的花生油和大豆油2种植物油中钾、钠离子进行检测;以国家标准法测定结果为参考标准值,并计算反胶束萃取分离分析方法对不同种类植物油种钾、钠的萃取效率,得到实验结果。
可知,不同植物油中同一种离子的含量基本相当,且不同植物油中钠离子的含量普遍比钾离子含量偏高;反胶束溶液萃取植物油中钾离子优于萃取钠离子的效果,由于反胶束萃取法中取样量大及萃取反应过程较复杂,导致反胶束萃取效率偏低,但通过对反胶束萃取条件优化,可进一步提高萃取效率。
试验采用反胶束萃取法对植物油中钾、钠元素进行富集浓缩处理,并通过火焰原子吸收光谱法对其含量进行测定,从而建立了一种快速分离富集及分析检测的方法,为快速分析植物油中钾钠离子的含量提供了一种有效途径。